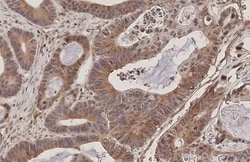
Invitrogen RANBP1 Recombinant Rabbit Monoclonal Antibody (HL2358) 100 &mu;L;

missing translation for 'onlineSavingsMsg'
Learn More
Learn More
Invitrogen™ RANBP1 Recombinant Rabbit Monoclonal Antibody (HL2358)


Rabbit Recombinant Monoclonal Antibody
Brand: Invitrogen™ MA550503
This item is not returnable.
View return policy
Description
RANBP1 Recombinant Monoclonal Antibody for Western Blot, ICC/IF, IHC (P)
Ran/TC4-binding protein, RanBP1, interacts specifically with GTP-charged RAN. RANBP1 encodes a 23-kD protein that binds to RAN complexed with GTP but not GDP. RANBP1 does not activate GTPase activity of RAN but does markedly increase GTP hydrolysis by the RanGTPase-activating protein (RanGAP1). The RANBP1 cDNA encodes a 201-amino acid protein that is 92% similar to its mouse homolog. In both mammalian cells and in yeast, RANBP1 acts as a negative regulator of RCC1 by inhibiting RCC1-stimulated guanine nucleotide release from RAN.
Specifications
| RANBP1 | |
| Recombinant Monoclonal | |
| 1 mg/mL | |
| PBS with no preservative | |
| P34022, P43487 | |
| RANBP1 | |
| Recombinant fragmemt of human RanBP1. | |
| 100 μL | |
| Primary | |
| Human, Mouse, Rat | |
| Antibody | |
| IgG |
| Immunohistochemistry (Paraffin), Western Blot, Immunocytochemistry | |
| HL2358 | |
| Unconjugated | |
| RANBP1 | |
| HpaII tiny fragments locus 9A; hpaII tiny fragments locus 9a protein; Htf9a; Htf9-a; Htf9-a/RanBP1; RAN binding protein 1; ran-binding protein 1; RANBP1; RANG; Ran-specific GTPase-activating protein; testis secretory sperm-binding protein Li 221n | |
| Rabbit | |
| Protein A | |
| RUO | |
| 19385, 360739, 5902 | |
| Store at 4°C short term. For long term storage, store at -20°C, avoiding freeze/thaw cycles. | |
| Liquid |
Product Content Correction
Your input is important to us. Please complete this form to provide feedback related to the content on this product.
Product Title
Spot an opportunity for improvement?Share a Content Correction